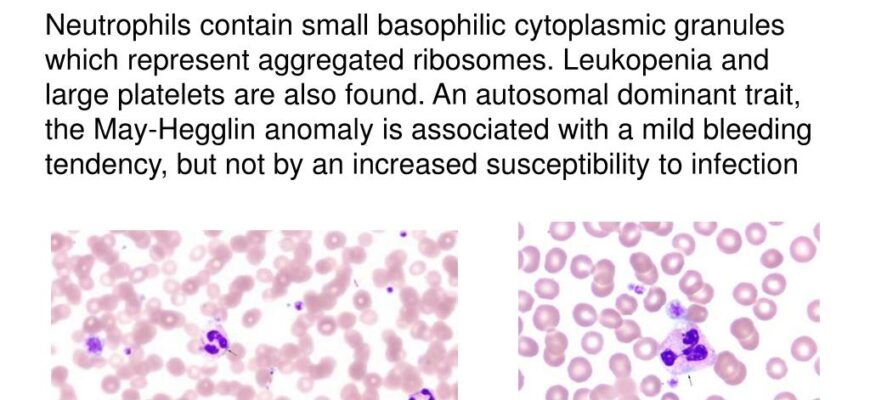

In a sport often lauded for its robust contests and tight margins, there are occasional eruptions that defy the norm. Such was the case in a recent Top 14 clash that saw Clermont Auvergne deliver a historic drubbing to newcomers Montauban, securing an 84-31 victory. While the scoreboard technicians may have needed a moment to catch their breath, the implications of this record-breaking affair extend far beyond mere point tallies, painting a perplexing picture of triumph amidst adversity.
A Deluge of Tries and a New Top 14 Benchmark
The numbers speak volumes: 13 tries for Clermont, 84 points on their side of the ledger, and a grand total of 115 points exchanged between the two teams. This monumental figure now stands as the highest combined points total ever recorded in a single Top 14 match. For fans of attacking rugby, it was a veritable feast, a try-scoring extravaganza that showcased Clermont`s offensive capabilities when operating at full throttle. The ease with which they breached Montauban`s defenses, time and again, suggested a team unleashed, playing with a freedom and precision that had been conspicuously absent in their earlier fixtures.
Montauban`s Baptism by Fire: The Hard Realities of Promotion
For US Montauban, the experience was less a feast and more a trial by fire. As a newly promoted side, their entry into the elite Top 14 competition was always destined to be challenging. While they managed to cross the try line themselves with a commendable 31 points, their defensive frailties were brutally exposed. This marks their second significant defeat of the season, a stark reminder of the chasm in quality and experience that often separates the top tier from the second division. The enthusiasm of promotion is quickly giving way to the harsh realities of a league where every point, every defensive set, and every breakdown battle is magnified.
The Paradox of Power: Clermont`s Puzzling Start
Herein lies the intriguing irony of this record-breaking performance. Despite their seemingly insurmountable victory, Clermont Auvergne finds itself languishing in 12th place in the Top 14 standings. Prior to this monumental win, they had suffered three consecutive defeats, a start that had raised more than a few eyebrows for a club of their stature. Historically a perennial contender, Clermont`s early season form suggested a team grappling with identity and consistency. This 84-point outburst, therefore, presents a fascinating paradox: was it a genuine turning point, a cathartic release of pent-up aggression and skill, or merely an anomaly against a struggling opponent?
“To score 84 points and still be flirting with the relegation zone is a testament to the unforgiving nature of the Top 14. One glorious afternoon does not erase the pain of three prior defeats, but it certainly offers a glimpse of what`s possible.”
Looking Ahead: A Defining Moment or a Statistical Aberration?
For Clermont, the challenge now shifts from scoring freely to consistently replicating that intensity and defensive resolve against more established opponents. Will this record-breaking win ignite their season, providing the confidence boost needed to climb the table? Or will it be viewed in hindsight as a spectacular but ultimately isolated incident, a temporary respite from deeper structural issues?
Montauban, on the other hand, must swiftly regroup. With only a single draw to their name and occupying 13th position (just one spot below Clermont, ironically), their path to survival in the Top 14 appears increasingly arduous. They must learn from the harsh lessons imparted by Clermont, shore up their defense, and find ways to convert their attacking moments into consistent points.
The Top 14 season is long and arduous. While the headlines will rightfully celebrate Clermont`s historic point haul, the true measure of this match`s significance will only become clear in the coming weeks and months, as both teams navigate the relentless demands of France`s premier rugby competition. For now, we are left with a memorable scoreline and a myriad of questions about what it truly signifies.